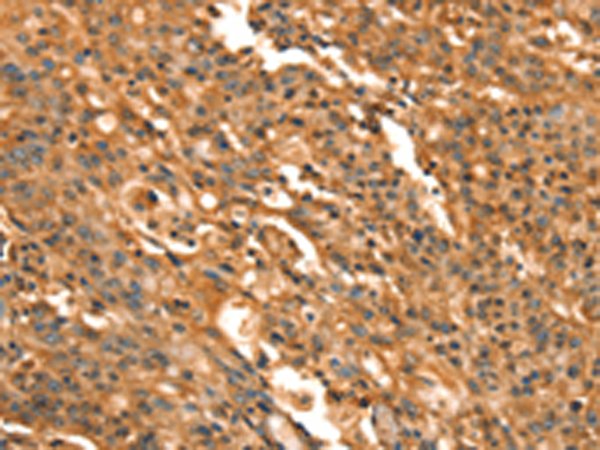

-
分类: 科研抗体货号: P11616别名: NBR13; Cav3.1; Ca(V)T.1应用: IHC反应种属: Human, Rat
-
分类: 科研抗体货号: P11617别名: MYSB; CAVB2; CACNLB2应用: IHC反应种属: Human, Mouse, Rat
-
分类: 科研抗体货号: P11633别名: CMS应用: WB,IHC反应种属: Human
-
分类: 科研抗体货号: P11615别名: BII; CACH6; Cav2.3; CACNL1A6应用: IHC反应种属: Human, Mouse, Rat
-
分类: 科研抗体货号: P11632别名: CD24A应用: WB,IHC反应种属: Human
-
分类: 科研抗体货号: P11614别名: CACH3; CACN4; PASNA; SANDD; Cav1.3; CCHL1A2; CACNL1A2应用: IHC反应种属: Human, Rat
-
分类: 科研抗体货号: P11630别名: CKR5; CCR-5; CD195; CKR-5; CCCKR5; CMKBR5; IDDM22; CC-CKR-5应用: IHC反应种属: Human, Mouse
-
分类: 科研抗体货号: P11613别名: TS; LQT8; CACH2; CACN2; CaV1.2; CCHL1A1; CACNL1A1应用: IHC反应种属: Human
-
分类: 科研抗体货号: P11629别名: CKb8; MIP3; Ckb-8; MIP-3; MPIF-1; SCYA23; Ckb-8-1; hmrp-2a; CK-BETA-8应用: IHC反应种属: Human
-
分类: 科研抗体货号: P11641别名: p50; Bp50; CDW40; TNFRSF5应用: IHC反应种属: Human, Mouse

鄂公网安备42018502007531号
鄂公网安备42018502007531号

